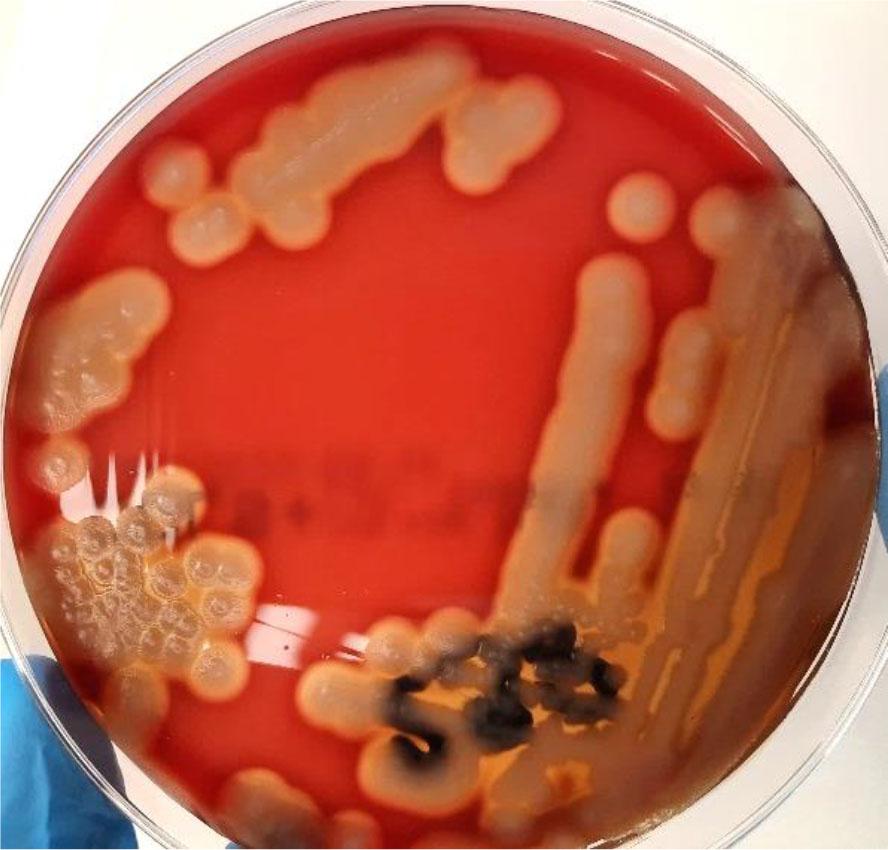
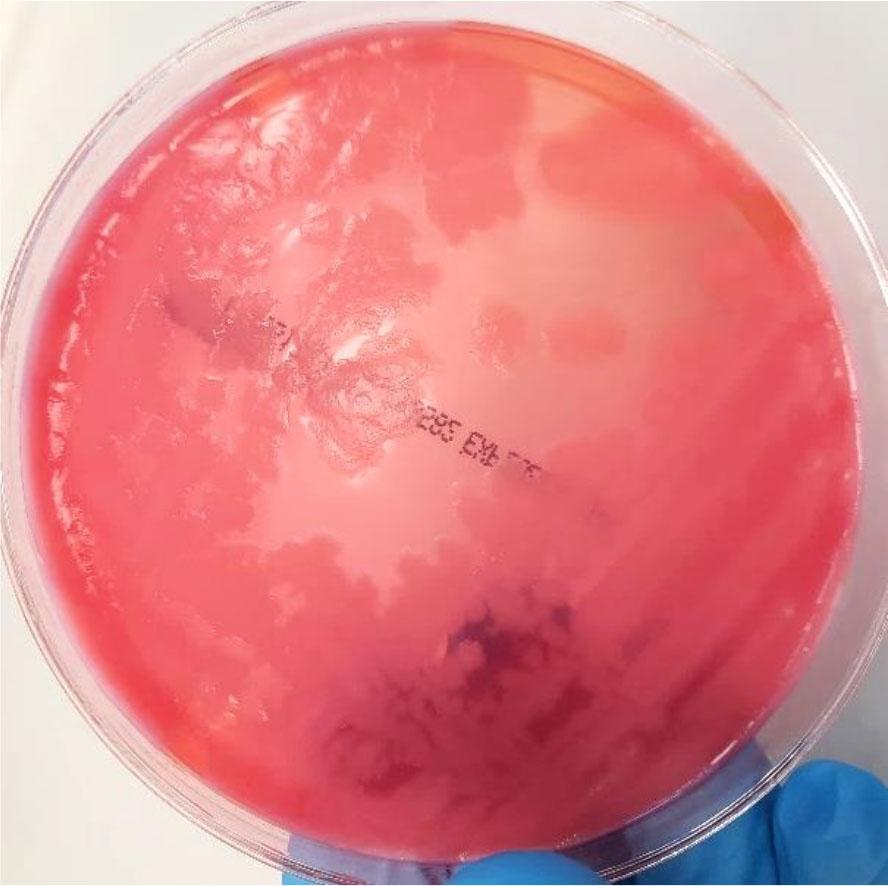

Fig. 1a.
Fig. 1b.
Fig. 2.

Fig. 3.

Fig. 4.

Results of identification using matrix-assisted laser desorption/ionisation–time-of-flight mass spectrometry (MALDI-TOF MS) and VITEK2 Corynebacterium (CBC) fluorogenic and analytical profile index for Coryneform bacteria (API CORYNE) tests for Corynebacterium spp_ isolated from one fallen alpaca
| Sample source | MALDI-TOF MS (score) | VITEK2 CBC (% probability) | API Coryne |
|---|---|---|---|
| colon (1A) | Candida lipolytica | Corynebacterium diphtheriae (91) | Corynebacterium diphtheriae (95) |
| small intestine (1A) | Corynebacterium stationis (9.560) | Corynebacterium sp. (97) | Corynebacterium diphtheriae (97) |
| small intestine (1A) | Corynebacterium stationis (9.465) | Corynebacterium minutissimum (96) | Corynebacterium sp. (89) |
| colon (1A) | Corynebacterium stationis (9.376) | Corynebacterium minutissimum (95) | Corynebacterium sp. (82) |
| colon (1A) | Corynebacterium stationis (8.985) | Corynebacterium minutissimum (93) | Corynebacterium sp. (91) |
| colon (1A) | Corynebacterium stationis (9.167) | Corynebacterium minutissimum (97) | Corynebacterium sp. (89) |
| small intestine (1A) | Corynebacterium xerosis (9.440) | Corynebacterium xerosis (98) | Corynebacterium sp. (85) |
Conditions for bacteria incubation on individual solid media
| Type of solid media | Incubation atmosphere | Temperature/time | Comment |
|---|---|---|---|
| Baird-Parker | aerobic | 37°C for 24 ± 2 h | The reading was made after 24h and after 48 h |
| OCLA | aerobic | 37°C for 24 ± 2 h | Negative plates were read again after 48 h |
| Yersinia CIN agar | aerobic | 3O°C/24h | The reading was made after 24h and after 48 h |
| Columbia agar with 5% sheep blood | aerobic | 37°C/24h | +/− 2h |
| Columbia agar with 5% sheep blood | anaerobic | 37°C/24h | +/− 2h |
| mCCD agar | anaerobic | 42°C/48h | Negative plates was read again after 48 h |
| CHROMagar Campylobacter | anaerobic | 42°C/48h | Negative plates was read again after 72 h |
| Chapman | aerobic | 37°C/24h | +/− 2h |
| MYP Agar | aerobic | 37°C/24h | Negative plates was read again after 48 h |
| MacConkey’s agar | aerobic | 37°C/24h | +/− 2h |
| CNA | aerobic | 37°C/24h | +/− 2h |
Results of identification using matrix-assisted laser desorption/ionisation–time-of-flight mass spectrometry (MALDI-TOF MS) and VITEK2 BCL test for Bacillus isolated from two alpacas
| Sample source | MALDI-TOF (score) | VITEK2 BCL (% probability) |
|---|---|---|
| rectum (2A) | Bacillus aeolinus (5.139) | Bacillus subtilis/Bacillus amyloliquefaciens/Bacillus atrophaeus (97) |
| small intestine (2A) | Bacillus altitudinis (8.713) | Bacillus subtilis/Bacillus amyloliquefaciens/Bacillus atrophaeus (95) |
| rectum (2A) | Bacillus anthraci 6.295) | Bacillus cereus (98) |
| colon (2A) | Bacillus cereus (9.279) | Bacillus cereus (98) |
| colon (2A) | Bacillus sp. (7.835) | Bacillus cereus (99) |
| colon (2A) | Bacillus cecembensis (5.993) | Bacillus pumilus (93) |
| colon (2A) | Bacillus flexus (5.375) | unidentified |
| small intestine (2A) | Bacillus licheniformis (9.476) | Bacillus licheniformis (99) |
| small intestine (2A) | Bacillus licheniformis (8.525) | Bacillus licheniformis (99) |
| colon (2A) | Bacillus licheniformis (4.744) | Bacillus licheniformis (91) |
| colon (2A) | Bacillus licheniformis (9.253) | Bacillus licheniformis (99) |
| rectum (2A) | Bacillus licheniformis (7.233) | Bacillus licheniformis (99) |
| small intestine (AH) | Bacillus pumilus (9.157) | Bacillus pumilus (92) |
| colon (2A) | Bacillus pumilus (9.547) | Bacillus pumilus (98) |
| colon (2A) | Bacillus pumilus (6.156) | Bacillus pumilus (96) |
| colon (2A) | Bacillus pumilus (8.884) | Bacillus pumilus (98) |
| colon (2A) | Bacillus subtilis (7.181) | Bacillus subtilis (98) |
| colon (2A) | Bacillus subtilis (6.428) | Bacillus subtilis (95) |
Results of identification using matrix-assisted laser desorption/ionisation–time-of-flight mass spectrometry (MALDI-TOF MS) and VITEK2 Anaerobic and Corynebacterium (ANC) fluorogenic test for Clostridium perfringens isolated from an alpaca which was healthy until its death (AH)
| Sample source | MALDI-TOF MS (score) | VITEK2 ANC (% probability) |
|---|---|---|
| small intestine (AH) | Clostridium perfringens (9.635) | Clostridium perfringens (95) |
| small intestine (AH) | Clostridium perfringens (9.665) | Clostridium perfringens (92) |
| colon (AH) | Clostridium perfringens (9.619) | Clostridium perfringens (95) |
| colon (AH) | Clostridium perfringens (9.664) | Clostridium perfringens (98) |
Results of identification using matrix-assisted laser desorption/ionisation–time-of-flight mass spectrometry (MALDI-TOF MS) and VITEK2 Gram-positive (GP) and analytical profile index for Staphylococcus (API Staph) tests for Gram-positive cocci isolated from three alpacas
| Sample source | MALDI-TOF (score) | VITEK2 GP (% probability) | API Staph (% probability) |
|---|---|---|---|
| colon (1A) | Staphylococcus aureus (9.380) | Staphylococcus aureus (97) | Staphylococcus aureus (94) |
| rectum (1A) | Staphylococcus aureus (9.410) | Staphylococcus aureus (99) | Staphylococcus aureus (96) |
| colon (1A) | Staphylococcus equorum (9.001) | Staphylococcus equorum (92) | Staphylococcus intermedius (90) |
| colon (1A) | Staphylococcus lentus (9.457) | Staphylococcus lentus (96) | Staphylococcus lentus (96) |
| rectum (2A) | Staphylococcus pseudintermedius (7.247) | Staphylococcus pseudintermedius (98) | Staphylococcus simulans (82) |
| small intestine (2A) | Staphylococcus sciuri (9.111) | Staphylococcus sciuri (86) | Staphylococcus sciuri (92) |
| small intestine (2A) | Staphylococcus sciuri (9,428) | Staphylococcus sciuri (95) | Staphylococcus sciuri (92) |
| small intestine (2A) | Staphylococcus sciuri (9.471) | Staphylococcus sciuri (95) | Staphylococcus sciuri (96) |
| colon (1A) | Staphylococcus sciuri (8.228) | Staphylococcus sciuri (95) | Staphylococcus sciuri (97) |
| colon (1A) | Staphylococcus sciuri (9.120) | Staphylococcus sciuri (95) | Staphylococcus sciuri (97) |
| colon (1A) | Staphylococcus sciuri (9.345) | Staphylococcus sciuri (95) | Staphylococcus sciuri (97) |
| colon (1A) | Staphylococcus sciuri (9.528) | Staphylococcus sciuri (97) | Staphylococcus sciuri (97) |
| colon (1A) | Staphylococcus sciuri (9.513) | Staphylococcus sciuri (95) | Staphylococcus sciuri (97) |
| colon (1A) | Staphylococcus sciuri (9.405) | Staphylococcus sciuri (95) | Staphylococcus sciuri (94) |
| colon (1A) | Staphylococcus sciuri (9.571) | Staphylococcus sciuri (87) | Staphylococcus sciuri (89) |
| colon (1A) | Staphylococcus sciuri (9.385) | Staphylococcus sciuri (88) | Staphylococcus sciuri (89) |
| rectum (2A) | Micrococcus luteus (9.169) | unidentified | Micrococcus sp. (77) |
| rectum (AH) | Lactococcus lactis subsp. cremoris (9.041) | Lactococcus lactis subsp. cremoris (9.041) | unidentified |
Results of identification using matrix-assisted laser desorption/ionisation–time-of-flight mass spectrometry (MALDI-TOF MS) and VITEK2 Gram-negative (GN) fluorogenic, analytical profile index for 20 Enterobacteriaceae (API 20E), and RapID ONE tests for Gram-negative Yersiniaceae, Morganellaceae and Pseudomonadaceae isolated from three alpacas
| Sample source | MALDI-TOF MS (score) | VITEK2 GN (% probability) | API 20E (% probability) | rapID ONE (% probability) |
|---|---|---|---|---|
| Yersiniaceae | ||||
| small intestine (2A) | Serratia odorifera (9.285) | Serratia odorifera (99) | Serratia odorifera 1 (97) | Serratia odorifera 1,2 (97) |
| colon (2A) | Serratia liquefaciens (9.098) | Serratia odorifera (97) | Serratia liquefaciens (99) | Serratia liquefaciens (98) |
| rectum (2A) | Serratia odorifera (9.606) | Serratia odorifera (99) | Serratia odorifera 1 (99) | Serratia odorifera 1,2 (97) |
| faeces (2A) | Serratia odorifera (9.654) | Serratia odorifera (98) | Serratia odorifera 1 (96) | Serratia odorifera 1,2 (97) |
| faeces (1A) | no spectrum | Serratia marcescens (99) | Serratia marcescens (97) | Serratia marcescens (98) |
| Morganellaceae | ||||
| rectum (AH) | Morganella morganii (9.362) | Morganella morganii subsp. morganii (99) | Morganella morganii (99) | Morganella morganii (99) |
| rectum (AH) | Morganella morganii (9.480) | Morganella morganii subsp. morganii (99) | Morganella morganii (98) | Morganella morganii (98) |
| small intestine (AH) | Providencia alcalifaciens (9.589) | Providencia alcalifaciens (97) | Providencia alcalifaciens/rustigianii (98) | Providencia alcalifaciens (98) |
| rectum (AH) | Providencia alcalifaciens (9.067) | Providencia alcalifaciens (98) | Providencia alcalifaciens/rustigianii (98) | Providencia alcalifaciens (99) |
| rectum (AH) | Providencia alcalifaciens (9.611) | Providencia alcalifaciens (98) | Providencia alcalifaciens/rustigianii (99) | Providencia alcalifaciens (96) |
| Pseudomonadaceae | ||||
| small intestine (1A) | Pseudomonas aeruginosa (8.239) | Pseudomonas aeruginosa (99) | Pseudomonas aeruginosa (99) | Pseudomonas aeruginosa (99) |
| rectum (1A) | Pseudomonas aeruginosa (8.856) | Pseudomonas aeruginosa (98) | Pseudomonas aeruginosa (98) | Pseudomonas aeruginosa (98) |
Results of identification using matrix-assisted laser desorption/ionisation–time-of-flight mass spectrometry (MALDI-TOF MS), VITEK2 Gram-positive (GP) for Gram-positive Enterococcaceae isolated from three alpacas
| Sample source | MALDI-TOF (score) | VITEK2 GP (% probability) |
|---|---|---|
| small intestine (1A) | Enterococcus faecium (9.721) | Enterococcus faecium (99) |
| rectum (1A) | Enterococcus gallinarum (9.705) | Enterococcus gallinarum (99) |
| small intestine (1A) | Enterococcus hirae (9.686) | Enterococcus hirae (99) |
| colon (2A) | Enterococcus hirae (9.618) | Enterococcus hirae (99) |
| colon (2A) | Enterococcus hirae (9.697) | Enterococcus hirae (99) |
| colon (2A) | Enterococcus hirae (9.670) | Enterococcus hirae (99) |
| rectum (2A) | Enterococcus hirae (9.591) | Enterococcus hirae (99) |
| rectum (2A) | Enterococcus hirae (9.694) | Enterococcus hirae (99) |
| small intestine (AH) | Enterococcus casseliflavus (9.616) | Enterococcus casseliflavus (98) |
| colon (2A) | Enterococcus casseliflavus (9.615) | Enterococcus casseliflavus (98) |
| rectum (2A) | Enterococcus casseliflavus (8.198) | Enterococcus casseliflavus (99) |
| rectum (AH) | Enterococcus casseliflavus (9.637) | Enterococcus casseliflavus (99) |
| rectum (AH) | Enterococcus casseliflavus (9.539) | Enterococcus casseliflavus (99) |
Results of identification using matrix-assisted laser desorption/ionisation–time-of-flight mass spectrometry (MALDI-TOF MS), VITEK2 Gram-negative (GN) fluorogenic, VITEK2 Gram-positive (GP), analytical profile index for 20 Enterobacteriaceae (API 20E), analytical profile index for 20 non-Enterobacteriaceae (API 20NE) and RapID NF Plus tests for different bacteria isolated from two alpacas
| Sample source Gram-negative | MALDI-TOF MS (score) | VITEK2 GN (% probability) | API 20E/API 20NE | RapID NF Plus |
|---|---|---|---|---|
| colon (1A) | Stenotrophomonas spp. (Xanthomonadaceae), (9.158) | Stenotrophomonas maltophilia (96%) | Stenotrophomonas maltophilia (99%) | unidentified |
| small intestine (2A) | Moraxella osloensis (Moraxellaceae), (9.365) | Moraxella group, (94) GN | Moraxella spp. (94) | Moraxella osloensis (97) |
| small intestine (2A) | Arcticiflavibacter luteus (Flavobacteriaceae), (5.436) | unidentified | unidentified | unidentified |
| colon (2A) | Leeuwenhoekiella nanhaiensis (Flavobacteriaceae), (5.259) | unidentified | unidentified | unidentified |
| small intestine (1A) | Ochrobactrum intermedium (9.574) (Brucellaceae) | Ochrobactrum anthropi (82) | Ochrobactrum anthropi (97) | Ochrobactrum anthropi (97) |
| colon (2A) | Sphingobacterium anhuiense (Sphingobacteriaceae) (9.158) | unidentified | unidentified | unidentified |
| colon (2A) | Thalassolituus oleivorans (5.545), (Oceanospirillaceae) | unidentified | unidentified | unidentified |
| Sample source Gram-positive | MALDI-TOF (score) | VITEK2 GP (probability %) | API STAPH | |
| rectum (2A) | Cellulosimicrobium cellulans (8.475) (Promicromonosporaceae) | unidentified | unidentified | |
| colon (2A) | Paenibacillus amylolyticus (6.065) (Paenibacillaceae) | Paenibacillus amylolyticus, BCL (93) | unidentified | |
| colon (1A) | Brachybacterium conglomeratum (7.247) | unidentified | unidentified | |
| rectum (2A) | Leuconostoc citreum (4.426) | Leuconostoc mesenteroides (97) | unidentified |
Results of identification using matrix-assisted laser desorption/ionisation–time-of-flight mass spectrometry (MALDI-TOF MS) and VITEK2 yeast (YST) fluorogenic test for Candida isolated from two alpacas
| Sample source | MALDI-TOF MS (score) | VITEK2 YST (% probability) |
|---|---|---|
| small intestine (1A) | Candida albicans (8.982) | Candida albicans (96) |
| small intestine (1A) | Candida albicans (6.608) | Candida albicans (98) |
| small intestine (1A) | Candida albicans (7.777) | Candida albicans (97) |
| small intestine (1A) | Candida albicans (5.434) | Candida albicans (91) |
| colon (1A) | Candida albicans (7.651) | Candida albicans (91) |
| colon (2A) | Candida haemulonii (4.777) | Candida haemulonii (95) |
| colon (1A) | Candida lipolytica (4.495) | Corynebacterium diphtheriae (91) |
| colon (1A) | Candida metapsilosis (4.683) | Candida ciferrii (89) |
Results of identification using matrix-assisted laser desorption/ionisation–time-of-flight mass spectrometry (MALDI-TOF MS) and VITEK2 Gram-negative (GN) fluorogenic, analytical profile index for 20 Enterobacteriaceae (API 20E), and RapID ONE tests for Gram-negative Enterobacteriaceae isolated from three alpacas
| Sample source | MALDI-TOF MS (score) | VITEK2 GN (% probability) | API 20E (% probability) | RapID ONE (% probability) |
|---|---|---|---|---|
| small intestine (1A) | Citrobacter braakii (9.003) | Citrobacter braakii (97) | Citrobacter freundii (94) | Citrobacter freundii (94) |
| colon (1A) | Citrobacter braakii (8.770) | Citrobacter braakii (89) | Citrobacter freundii (92) | Citrobacter freundii (90) |
| rectum (1A) | No spectrum | Citrobacter freundii (95) | Citrobacter freundii (98) | Citrobacter freundii (96) |
| rectum (1A) | Citrobacter freundii (9.617) | Citrobacter freundii (95) | Citrobacter freundii (92) | Citrobacter freundii (95) |
| faeces (1A) | Citrobacter freundii (9.533) | Citrobacter braakii (89) | Citrobacter braakii (92) | Citrobacter freundii (90) |
| faeces (2A) | Citrobacter freundii (8.771) | Citrobacter freundii (95) | Citrobacter freundii (95) | Citrobacter freundii (95) |
| colon (1A) | Enterobacter cloacae (9.440) | Enterobacter cloacae complex (95) | Enterobacter cloacae (97) | Enterobacter cloacae (92) |
| colon (1A) | Enterobacter cloacae (9.607) | Enterobacter cloacae complex (97) | Enterobacter cloacae (96) | Enterobacter cloacae (93) |
| colon (1A) | Enterobacter cloacae (9.543) | Enterobacter cloacae complex (96) | Enterobacter cloacae (97) | Enterobacter cloacae (96) |
| colon (1A) | Enterobacter cloacae (9.010) | Enterobacter cloacae complex (95) | Enterobacter cloacae (96) | Enterobacter cloacae (95) |
| rectum (2A) | Enterobacter cloacae (9.539) | Enterobacter cloacae complex (96) | Enterobacter cloacae (98) | Enterobacter cloacae (95) |
| faeces (2A) | Enterobacter cloacae (9.573) | Enterobacter cloacae complex (97) | Enterobacter cloacae (96) | Enterobacter cloacae (97) |
| small intestine (2A) | Enterobacter gergoviae (9.170) | Enterobacter cloacae complex (94) | Enterobacter gergoviae (99) | Enterobacter gergoviae (99) |
| colon (2A) | Enterobacter hormaechei (9.617) | Enterobacter cloacae complex (94) | Enterobacter cloacae (91) | Enterobacter cloacae (89) |
| rectum (1A) | Enterobacter ludwigii (9.042) | Enterobacter cloacae complex (94) | Enterobacter cloacae (94) | Enterobacter cloacae (86) |
| small intestine (1A) | Escherichia coli (9.691) | Escherichia coli (99) | Escherichia coli (99) | Escherichia coli (99) |
| small intestine (1A) | Escherichia coli (9.679) | Escherichia coli (99) | Escherichia coli (99) | Escherichia coli (99) |
| colon (1A) | Escherichia coli (9.646) | Escherichia coli (99) | Escherichia coli (99) | Escherichia coli (99) |
| colon (1A) | Escherichia coli (9.088) | Escherichia coli (99) | Escherichia coli (99) | Escherichia coli (99) |
| rectum (1A) | Escherichia coli (9.613) | Escherichia coli (99) | Escherichia coli (99) | Escherichia coli (99) |
| rectum (1A) | Escherichia coli (9.550) | Escherichia coli (99) | Escherichia coli (99) | Escherichia coli (99) |
| small intestine (AH) | Escherichia coli (9.616) | Escherichia coli (99) | Escherichia coli (99) | Escherichia coli (99) |
| small intestine (AH) | Escherichia coli (9.509) | Escherichia coli (99) | Escherichia coli (99) | Escherichia coli (99) |
| small intestine (AH) | Escherichia coli (9.587) | Escherichia coli (99) | Escherichia coli (99) | Escherichia coli (99) |
| small intestine (AH) | Escherichia coli (9.594) | Escherichia coli (99) | Escherichia coli (99) | Escherichia coli (99) |
| small intestine (AH) | Escherichia coli (9.578) | Escherichia coli (99) | Escherichia coli (99) | Escherichia coli (99) |
| small intestine (AH) | Escherichia coli (9.649) | Escherichia coli (99) | Escherichia coli (99) | Escherichia coli (99) |
| small intestine (AH) | Escherichia coli (9.603) | Escherichia coli (99) | Escherichia coli (99) | Escherichia coli (99) |
| small intestine (AH) | Escherichia coli (9.568) | Escherichia coli (99) | Escherichia coli (99) | Escherichia coli (99) |
| colon (AH) | Escherichia coli (9.568) | Escherichia coli (99) | Escherichia coli (99) | Escherichia coli (99) |
| colon (AH) | Klebsiella pneumoniae (9.132) | Klebsiella pneumoniae subsp. pneumoniae (96) | Klebsiella pneumoniae subsp. pneumoniae (97) | Klebsiella pneumoniae (98) |
| colon (AH) | Klebsiella pneumoniae subsp. pneumoniae (9.063) | Klebsiella pneumoniae subsp. pneumoniae (99) | Klebsiella pneumoniae subsp. pneumoniae (96) | Klebsiella pneumoniae (98) |